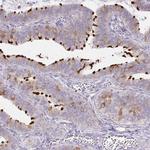
DNAI2 Antibody in Immunohistochemistry (IHC)

Search
Invitrogen
DNAI2 Polyclonal Antibody
{{$productOrderCtrl.translations['antibody.pdp.commerceCard.promotion.promotions']}}
{{$productOrderCtrl.translations['antibody.pdp.commerceCard.promotion.viewpromo']}}
{{$productOrderCtrl.translations['antibody.pdp.commerceCard.promotion.promocode']}}: {{promo.promoCode}} {{promo.promoTitle}} {{promo.promoDescription}}. {{$productOrderCtrl.translations['antibody.pdp.commerceCard.promotion.learnmore']}}
产品信息
PA5-62215
种属反应
宿主/亚型
分类
类型
抗原
偶联物
形式
浓度
规格
纯化类型
保存液
内含物
保存条件
运输条件
RRID
产品详细信息
Immunogen sequence: IVYVYVKKRS EFGKQCNFSD RQAELNIDIM PNPELAEQFV ERNPVDTGIQ CSISMSEHEA NSERFEMETR GVNHVEGGWP KDVNPLELEQ TIRFRKKVEK DENYVNAIMQ LGSIMEHCIK QNNAI
Highest antigen sequence identity to the following orthologs: Mouse - 90%, Rat - 91%.
靶标信息
The protein encoded by this gene belongs to the dynein intermediate chain family, and is part of the dynein complex of respiratory cilia and sperm flagella. Mutations in this gene are associated with primary ciliary dyskinesia type 9. Alternatively spliced transcript variants encoding different isoforms have been noted for this gene.
仅用于科研。不用于诊断过程。未经明确授权不得转售。
篇参考文献 (0)
生物信息学
蛋白别名: Axonemal dynein intermediate chain 2; Dynein axonemal intermediate chain 2; dynein, axonemal, intermediate polypeptide 2
基因别名: CILD9; DIC2; DNAI2; oda6
UniProt ID: (Human) Q9GZS0
Entrez Gene ID: (Human) 64446